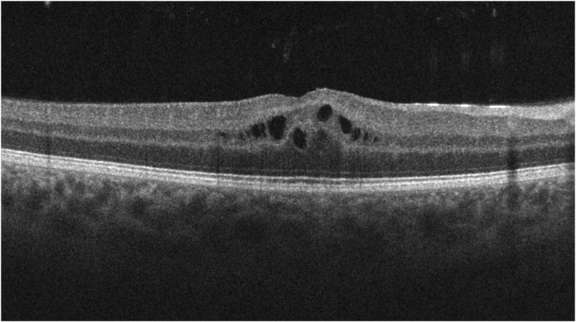

Oedeme Maculaire Cystoide
Maculopathie kystique versus œdème maculaire cystoïde Kystes intrarétiniens (ou espaces kystiques Lingao et al)= altération de la structure rétinienne sans ou avec peu de rupture de la barrière hématorétinienne Ganesh et al 11 Ganesh et al 11 D’après Hirakawa et al, 1999.

Oedeme maculaire cystoide. L’œdème maculaire cystoïde (OMC) est une cause primaire de baisse d’acuité visuelle après chirurgie de la cataracte ou après chirurgie vitréorétinienne. 1 retina 18 oct;38(10)7380 doi /iae acute pseudophakic cystoid macular edema imaged by optical coherence tomography angiography. Par définition, l’œdème maculaire est une affection de la macula, la région se trouvant au fond de l’œil et dans l’axe pupillaire Cette partie de l’œil mesure environ 1 mm et comporte un nombre important de photorécepteurs, appelés les cônes.
Maculaire diabétique Synthèse des différentes options Dr Amélie LecleireCollet* *Clinique Mathilde, Rouen;. Avec un œdème maculaire kystique chronique dû à une traction antéropostérieure, une vitrectomie peut être réalisée La membrane épirétinienne maculaire peut parfois être à l'origine d'un œdème maculaire kystique avec atteinte des capillaires péripoviaux Dans certains cas, l'ablation chirurgicale de la membrane peut être efficace. D'œdème maculaire cystoïde, elles peuvent diminuer la dose, ce qui permet à la rétine de retrouver sa fonction normale, tout en bénéficiant de la niacine 7,8 Dosage Pour ceux qui envisagent de prendre des doses élevées de niacine, le meilleur conseil semble être de commencer.
Introduction L’œdème maculaire post opératoire est une complication bien connue après chirurgie de la cataracte, mais il peut compliquer bien d’autres chirurgies endoculaires et d’autres traitements (chirurgie extraoculaire et traitements au laser). Maculaire qui a authentifi é cet œdème maculaire cystoïde, plus important sur l’œil droit que sur l’œil gauche (fi gure 1, p 105) Nous avons alors commencé un traitement par acétazolamide per os Cependant, du fait d’un rein unique par malformation, le traitement a dû être arrêté devant l’apparition. Médicament antifacteur de nécrose tumorale pour le traitement d’un gonflement à l'arrière de l'œil (œdème maculaire) due à une maladie oculaire inflammatoire (uvéite) Photocoagulation au laser en monothérapie pour l'œdème maculaire diabétique Tomographie par cohérence optique (TCO) pour la détection de l'oedème maculaire chez des patients présentant une rétinopathie.
L’œdème maculaire (OM) est un épaississement maculaire, résultat d’une accumulation de liquide dans la rétine autour de la fovéa Il s’agit d’une affection non spécifique qui doit être considérée comme une réponse de la région maculaire à une modification de l’environnement. Je voudrais imprimer votre commentaire mais ne sais pas. L’œdème maculaire cystoïde (OMC) est une cause primaire de baisse d’acuité visuelle après chirurgie de la cataracte ou après chirurgie vitréorétinienne L’incidence de l’œdème maculaire cystoïde clinique au décours de la chirurgie de la cataracte moderne est de 0,1–2,35 % Des conditions préexistantes telles qu’un diabète sucré et une uvéite, aussi bien que des complications interopératoires peuvent entraïner un risque d’œdème maculaire cystoïde.
Je découvre ce qu'est un œdème maculaire cystoïde;. Mie maculaire et des remaniements pigmentés rétrofovéaux L’œdème maculaire est fréquemment cystoïde, en particulier dans les formes non ischémiques Certaines occlusions veinulaires proches de la fovéa sont responsables d’un œdème maculaire et ne doivent pas être confondues avec une anastomose rétinocho. Hôpital Lariboisière, Paris tableau 1 – imagerie optimale d’un œdème maculaire diabétique photographies maculaires couleurs, bleu, vert, et en autofluorescence ± panoramique couleurs pour la périphérie rétinienne.
L'oedème maculaire cystoïde (OMC) est une affection rétinienne assez fréquente, et qui entraîne une baisse de la vision En fonction de son étiologie, on assistera à une disparition de cet oedème ou bien, au contraire, à une persistance des lésions L'OMC correspond à la formation de cavités (logettes) au sein de la couche rétinienne plexiforme externe (couche des fibres de Henlé), et/ou dans la couche granuleuse interne. Translations in context of "cystoïde" in FrenchEnglish from Reverso Context Des cas d 'œ dème maculaire cystoïde ont été rapportés avec GANFORT. Introduction L’œdème maculaire post opératoire est une complication bien connue après chirurgie de la cataracte, mais il peut compliquer bien d’autres chirurgies endoculaires et d’autres traitements (chirurgie extraoculaire et traitements au laser).
Moi je suis soigné à l'oeil droit pour un œdème maculaire mais à cause de 2 décollements complets de rétine (donc 2 fois décollements de la macula), c'est diffèrent de ton cas mais on fait un peu partie du même club,. Symptômes de l'œdème maculaire L'œdème maculaire provoque peu de symptômes, en fait, dans la plupart des cas, il est indolore À mesure que la dégénérescence cellulaire progresse, le patient peut commencer à remarquer une perte d'acuité visuelle, une vision trouble, perception des images avec manque de couleur et déformation des objets ou difficulté à les apprécier en détail. L’œdème maculaire étant la principale cause de baisse d’acuité visuelle lors des occlusions veineuses rétiniennes, son pronostic recoupe celui des occlusions veineuses rétiniennes en général, entravé par la possibilité de conversion ischémique Le diagnostic d’occlusion veineuse rétinienne est clinique et ne nécessite pas d.
œdème maculaire cystoïde, médicament, toxicité zzzzzz * Service d’Ophtalmologie, Hôpital Erasme, Université Libre de Bruxelles, Bruxelles Bull Soc belge Ophtalmol,304, 7176, 07 71 DÉFINITION L’œdème maculaire cystoïde (OMC) est une accumulation maculaire de liquide avec formation. Définition du terme Oedème maculaire cystoïde L'oedème maculaire cystoïde est une affectionrétinienne assez fréquente, correspondant à la formation, au sein de la rétine, de cavités, ou logettes, disposées en rayons de roue Cette affection est responsable de troubles de la vision à type de diminution de l'acuité visuelle et parfois de métamorphopsies (vision ondulée des lignes droites) ou de scotomecentral. Dr Sébastien Olivier, ophtalmologiste, Hôpital MaisonneuveRosemont, nous parle de l'œdème maculaire, une complication à l'œil Pour en savoir plus wwwdiab.
L'article "oedeme maculaire cystoide" m'interesse car je suis impactée par ce problème depuis une opération de cataracte récente;. Près et chez qui un examen OCT maculaire a été réalisé L’épaisseur maculaire moyenne était de 2,4µm avec des extrêmes de 269,3µm et 309,2µmL’œdème maculaire était cystoïde (Fig 1) dans 45,7% des cas, non cystoïde dans 42,9% des cas et mixte dans 2,9% des cas L’œdème n’était ni cystoïde, ni non cystoïde. Des cas d 'œ dème maculaire cystoïde ont été rapportés avec GANFORT Cystoid macular oedema has been reported with GANFORT Fréquence indéterminée œ dème maculaire cystoïde Not known cystoid macular oedema Affections oculaires œ dème maculaire cystoïde, amblyopie toxique Cystoid macular oedema, toxic amblyopia L'oedème maculaire cystoïde (OMC) est souvent.
Œdème maculaire cystoïde du pseudophake traitement des formes aiguës et chroniques • L’œdème maculaire du pseudophake fait référence à une inflammation postchirurgicale survenant dans les suite d’une chirurgie de la cataracte • Incidence dépend fortement des moyens utilisés pour le dépister. Synonymes OEDEME MACULAIRE CYSTOIDEsignaler un problème synonymes OEDEME MACULAIRE CYSTOIDE signaler un problème Oedème maculaire cystoïde (n) ( Cismef) Oedème maculaire ( Cismef), Oedème. L'oedème maculaire cystoïde (OMC) est souvent responsable d'une perte visuelle inattendue et peut se manifester 4 à 6 semaines après l'opération Cystoid macular oedema (CMO) is often the cause of unexpected visual loss and may become evident 46 weeks after surgery.
OEDEME MACULAIRE DIABETIQUE Nouvelles approches th – A free PowerPoint PPT presentation (displayed as a Flash slide show) on PowerShowcom id 2a7135MTNiM. Des cas d 'œ dème maculaire cystoïde ont été rapportés avec GANFORT Cystoid macular oedema has been reported with GANFORT Fréquence indéterminée œ dème maculaire cystoïde. L’œdème maculaire est lié à l’accumulation de fluide dans les couches rétiniennes, tout autour de la fovea Cet œdème contribue à une diminution de vision liée à l’altération des.
L'oedème maculaire cystoïde (OMC) est souvent responsable d'une perte visuelle inattendue et peut se manifester 4 à 6 semaines après l'opération Cystoid macular oedema (CMO) is often the cause of unexpected visual loss and may become evident 46 weeks after surgery. L’œdème maculaire cystoïde (OMC) est une cause primaire de baisse d’acuité visuelle après chirurgie de la cataracte ou après chirurgie vitréorétinienne L’incidence de l’œdème. Moi je suis soigné à l'oeil droit pour un œdème maculaire mais à cause de 2 décollements complets de rétine (donc 2 fois décollements de la macula), c'est diffèrent de ton cas mais on fait un peu partie du même club,.
Œdème maculaire cystoïde (CME) L'œdème maculaire cystoïde ou CME, est un trouble indolore qui affecte la rétine centrale ou la macula Résultats Plusieurs zones de liquide ressemblant à des kystes (cystoïdes) apparaissent dans la macula. Un œdème maculaire peut entraïner une baisse d’acuité visuelle centrale supplémentaire L’angiographie à la fluorescéine et/ou la tomographie par cohérence optique permet de détecter la présence d’un œdème maculaire chez 10 à % des patients atteints de rétinite pigmentaire (RP). Mie maculaire et des remaniements pigmentés rétrofovéaux L’œdème maculaire est fréquemment cystoïde, en particulier dans les formes non ischémiques Certaines occlusions veinulaires proches de la fovéa sont responsables d’un œdème maculaire et ne doivent pas être confondues avec une anastomose rétinocho.
Des cas d 'œ dème maculaire cystoïde ont été rapportés avec GANFORT Cystoid macular oedema has been reported with GANFORT Fréquence indéterminée œ dème maculaire cystoïde. Ozurdex est un implant biocompatible homologué pour le traitement de l'œdème maculaire cystoïde (OCM) après une occlusion de veine rétinienne Nous rapportons un cas de déplacement du vitré antérieur d'Ozurdex, en discutant du mécanisme possible et de ses résultats. "Quand la chirurgie de la cataracte se passe bien, a priori il n'y a pas beaucoup de risques en postopératoire sauf un qui est l'oedème maculaire cystoïdeL'œdème maculaire cystoïde est une petite réaction de la macula après l'intervention chirurgicale, elle n'est absolument pas liée à la chirurgie On peut faire une chirurgie absolument magnifique et avoir malheureusement un.
Œdème maculaire Contrôleur des symptômes Les causes possibles comprennent Rétinopathie diabétique Consultez maintenant la liste complète des causes et des maladies possibles Parlez à notre Chatbot pour affiner les résultats de votre recherche. Des cas d 'œ dème maculaire cystoïde ont été rapportés avec GANFORT Cystoid macular oedema has been reported with GANFORT Fréquence indéterminée œ dème maculaire cystoïde. Introduction L’oedeme maculaire cystoïde (OMC) est une des causes de mauvaiserécupération visuelle après chirurgie de décollement de rétine (DDR) avec succèsanatomique L’objectif de cette étude est d’évaluer l’incidence de l’OMC après premièrechirurgie de décollement de rétine et d’identifier les facteurs associés au risque de survenued’OMC post opératoire.
L’œdème maculaire des membranes peut être initial ou secondaire au pelage Les membranes les plus actives sont responsables d’un épaississement rétinien visible et mesurable en tomographie à cohérence optique (optical coherence tomography ou OCT) qui peut être assimilé à un œdème intrarétinien diffus lorsqu’il dépasse 300 µ en spectraldomain optical coherence tomography. Des cas d 'œ dème maculaire cystoïde ont été rapportés avec GANFORT Cystoid macular oedema has been reported with GANFORT Fréquence indéterminée œ dème maculaire cystoïde. Le Pr Coscas, éminent spécialiste, a réuni autour de lui les meilleurs experts internationaux pour faire le point sur l’œdème maculaire, maladie allant de la simple diminution ou déformation de la vision ou pouvant s’avérer plus sévère et handicapante lorsqu’elle est associée au diabète Après avoir passé en revue la physiologie et le diagnostic, les auteurs abordent les.
GuexCrosier Y, OtheninGirard P, Herbort CP (1992) Traitement différencié de l’œdème maculaire cystoide inflammatoire postopératoire et secondaire aux uvéites Klinische Monatsbläter Augenheilkunde 0 367–367 CrossRef Google Scholar. L'œdème maculaire est, depuis de nombreuses années, l'un des problèmes les plus importants dans les pathologies rétiniennes, car toute atteinte de la macula a un effet immédiat sur la vision et l'acuité visuelle centrale, et peut affecter d'une manière importante la qualité de vie du patient. A un stade tardif, on parle d’œdème maculaire cystoïde lorsque l’accumulation du liquide extracellulaire se fait dans des logettes concentriques à la fovéola Dans ce cas les patients se plaignent d’une baisse d’acuité visuelle associée à des métamorphopsies (déformation des images) avec parfois un scotome central.
L'œdème maculaire est parfois appelé œdème maculaire cystoïde pour préciser que l'accumulation de liquide s'effectue dans des petites cavités (logettes) à type de kystes. 1 retina 18 oct;38(10)7380 doi /iae acute pseudophakic cystoid macular edema imaged by optical coherence tomography angiography. œdème maculaire cystoïde Voici une complication de la chirurgie de la cataracte, de gravité moyenne, appelée "œdème maculaire cystoïde", qui correspond à une inflammation de la macula (il serait correct de baptiser ce syndrome "maculite", mais ce terme n'est pas consacré par l'usage) Sous le trait rouge vertical, la macula (normalement noire sur ce cliché d'angiographie à la fluorescéine) est soufflée de logettes pleines d'œdème, qui dessinent comme une couronne de pétales.
Principale cause de malvoyance chez les patients diabétiques, l’œdème maculaire diabétique (OMD) est défini par un épaississement au niveau de la macula lié à une accumulation de liquide dans la rétine (1)Sa prévalence globale est estimée à 7 % d’après les dernières données des études internationales (2)Elle varie selon la durée du diabète ainsi que le niveau de. Bonjour j ai fait une opération de la cataracte il y a un an tout sest bien passéMais 2 mois après ma vision est devenu flou On m a fait une capsuloscopie qui na rien donnéL' oct a montré alors un œdème maculaire J ai été traité par un corticoïde en goutte L, œdème a disparue mais la tension est montée (je suis sous ganfort depuis des années)On a areté les corticoïdes. L’OCT maculaire mettait en évidence un œdème maculaire cystoïde associé à un décollement séreux rétinien Le traitement par anti inflammatoire non stéroïdien local et corticoïde est continué en augmentant la posologie sans succès Trois Injections intravitréennes d’antiVEGF par aflibercept sont alors réalisées.
Des cas d 'œ dème maculaire cystoïde ont été rapportés avec GANFORT Cystoid macular oedema has been reported with GANFORT Fréquence indéterminée œ dème maculaire cystoïde. GuexCrosier Y, OtheninGirard P, Herbort CP (1992) Traitement différencié de l’œdème maculaire cystoide inflammatoire postopératoire et secondaire aux uvéites Klinische Monatsbläter Augenheilkunde 0 367–367 CrossRef Google Scholar. Oedème maculaire cystoïde Terme de bas niveau MedDRA Oedème maculaire cystoïde (maladie) Concept SNOMED CT oedème maculaire cystoïde Concept TUV Alignements automatiques exacts (par équipe CISMeF) Oedème maculaire cystoïde Descripteur PASCAL Oedème maculaire cystoïde Terme HPO Oedème maculaire cystoïde Effet secondaire TUV.
L’œdème maculaire étant la principale cause de baisse d’acuité visuelle lors des occlusions veineuses rétiniennes, son pronostic recoupe celui des occlusions veineuses rétiniennes en général, entravé par la possibilité de conversion ischémique Le diagnostic d’occlusion veineuse rétinienne est clinique et ne nécessite pas d. Schisis maculaire par fossette colobomateuse de la papille Kystes maculaires persistants post Décollement de Rétine 7 INFLAMATION ET TUMEURS Œdème maculaire cystoïde du pseudophake Œdème maculaire cystoïde des uvéites chroniques Maculopathie cystoïde dans la Rétinopathie Pigmentaire. Je découvre ce qu'est un œdème maculaire cystoïde;.
LES OEDÈMES MACULAIRES CYSTOÏDES (OMC) NEU F* ABSTRACT Cystoid macular edema is a known side effect of different systemic and local medications Nicotinic acid used as a hypolipemiant agent can cause cystoid macular edema Local adrenergic antiglaucomatous drugs. Introduction La vitrectomie peut permettre de relâcher les tractions vitréorétiniennes antéropostérieures et tangentielles créant et entretenant parfois l'oedème maculaire diabétique Le but de ce travail est d'évaluer l'efficacité de ce moyen thérapeutique Matériel et méthodes Les dossiers de 15 patients diabétiques, dont 4 opérés aux 2 yeux, ont été colligés de façon.

Prise En Charge Du Syndrome De Necrose Retinienne Aigue Complique D œdeme Maculaire Cystoide Sciencedirect
.jpg)
Cours

Retine Archives Page 8 Sur 8 Realites Ophtalmologiques
Oedeme Maculaire Cystoide のギャラリー

John Libbey Eurotext Medecine Therapeutique Endocrinologie Traitement De L œdeme Maculaire

œdeme Maculaire Comment Se Produit Il Quel Est Le Traitement Icr

Ed œdeme Maculaire Symptomes Causes Et Traitement Area Oftalmologica

œdeme Maculaire Comment Se Produit Il Quel Est Le Traitement Icr

Rapport Sfo 16 œdemes Maculaires

Cours Retinopathie Diabetique

Atlasrleye Membranes Epiretiniennes Maculaires

œdeme Maculaire Cystoide Precoce Et Persistant Apres Une Sclerectomie Profonde Non Perforante Spnp A Propos D Un Cas Sfo Online Societe Francaise D Ophtalmologie

Diabete Dr Patrick Loriaut Chirurgien Ophtalmologiste Paris

Pdf Prise En Charge Du Syndrome De Necrose Retinienne Aigue Complique D œdeme Maculaire Cystoide Management Of Acute Retinal Necrosis Syndrome With Cystoid Macular Edema A Case Report Semantic Scholar

Maladies De La Retine Snof

Rapport Sfo 16 œdemes Maculaires

Rapport Sfo 16 œdemes Maculaires

Cours

A Aspect Du Fond D œil De L œil Droit Hyalite Et Tac Open I

Oedeme Maculaire Cystoide Du Cas 2 Download Scientific Diagram

Un Oedeme Maculaire Cystoide Revelateur D Un Melanome De La Choroide Figure 3

œdeme Maculaire Au Cours Des Uveites Sciencedirect

Occlusions Veineuses Retiniennes Ovr Docteur Naoun

L œdeme Maculaire Tout Sur Cette Affection De La Retine

John Libbey Eurotext Medecine Therapeutique Endocrinologie Traitement De L œdeme Maculaire

œdeme Maculaire Cystoide

John Libbey Eurotext Medecine Therapeutique Endocrinologie Traitement De L œdeme Maculaire

Atlasrleye Trou Maculaire Idiophatique

œdeme Maculaire Cystoide Chez Un Patient Traite Par Ibrutinib Pour Lymphome Non Hodgkinien A Cellule B Sfo Online Societe Francaise D Ophtalmologie

Oedeme Maculaire Symptomes Causes Traitement Top Sante

Rapport Sfo 16 œdemes Maculaires

Oedeme Maculaire Cystoide Du Cas 2 Download Scientific Diagram

Oedeme Maculaire Cystoide Snof

Galerie Heidelberg Engineering

Photos

Rapport Sfo 16 œdemes Maculaires

Toxicite Medicamenteuse Et Ophtalmologie Revue Medicale Suisse

Prise En Charge De L œdeme Maculaire Diabetique Diabetologie Pratique

œdeme Maculaire Cystoide Revelateur D Une Necrose Sclerale Secondaire A Une Indentation Sclerale Sciencedirect
.jpg)
Cours
Logettes En Oct Faut Il Toujours Injecter

Rapport Sfo 16 œdemes Maculaires

Un Cas D Uveite Intermediaire Precurseur De L Encephalomyelite Aigue Disseminee Adem Chez Un Adolescent œil

œdeme Maculaire Du Diagnostic A Sa Prise En Charge

Diabete Dr Patrick Loriaut Chirurgien Ophtalmologiste Paris

Oedeme Retinien En Oct

John Libbey Eurotext Sang Thrombose Vaisseaux Les Occlusions Veineuses Retiniennes

œdeme Maculaire Diabetique Institut De La Macula

Rapport Sfo 16 œdemes Maculaires

Chirurgie De La Cataracte En Terrain Inflammatoire Quelques Principes Mon Oeil

Un Oedeme Maculaire Cystoide Revelateur D Un Melanome De La Choroide Figure 4

Cours Retinopathie Diabetique

Cours Retinopathie Diabetique

Rapport Sfo 16 œdemes Maculaires

John Libbey Eurotext Medecine Therapeutique Endocrinologie Traitement De L œdeme Maculaire

Oedeme Maculaire Cystoide Snof

Baisse D Acuite Visuelle Postoperatoire Avec œdeme Maculaire

Rapport Sfo 16 œdemes Maculaires

Atlasrleye Sarcoidose

Smartfiches Medecine Smartfiches

Cours

Oedeme Maculaire Cystoide Archives Pratiques En Ophtalmologie

Rapport Sfo 16 œdemes Maculaires

Rapport Sfo 16 œdemes Maculaires

Prise En Charge De L œdeme Maculaire Diabetique Diabetologie Pratique

œdeme Maculaire Cystoide Traite Avec Succes Par Cryotherapie Dans Une Retinite Pigmentaire Avec Exsudation Retinienne En Manteau œil

Oedeme Retinien En Oct

Oedeme Maculaire Cystoide Du Cas 2 Download Scientific Diagram

Atlasrleye Membranes Epiretiniennes Maculaires

Le Syndrome D Irvine Gass Est Un œdeme Oct Optical Coherence Tomography Facebook

A Image Infrarouge Et Oct Optical Coherence Tomography Spectralis Download Scientific Diagram

Oedeme Maculaire Cystoide Du Cas 2 Download Scientific Diagram

Un Oedeme Maculaire Cystoide Revelateur D Un Melanome De La Choroide Figure 2

Oedeme Maculaire Cystoide Archives Pratiques En Ophtalmologie

œdeme Maculaire Cystoide Postchirurgical Springerlink

La Maculopathie œdemateuse Ou œdeme Maculaire Diabetique Journees Macula



